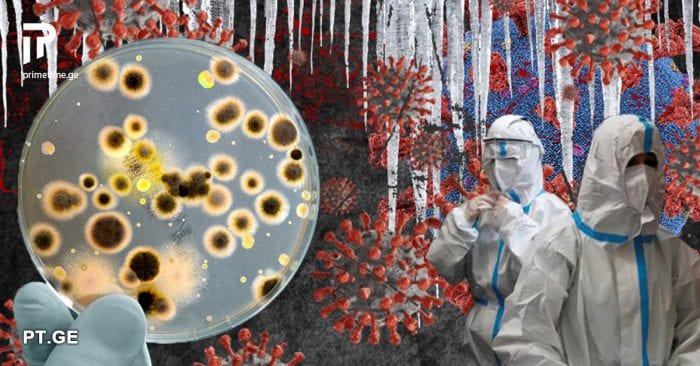
რამდენი ადამიანი გარდაიცვალა კორონავირუსით 2021 წელს – რიცხვები შემაშფოთებელია

უკვე ორი წელია მთელი მსოფლიო კორონავირუსის პანდემიას ებრძვის.
2020 წელს, ჯანდაცვის მსოფლიო ორგანიზაციის მიერ, ავადმყოფობათა და ჯანმრთელობასთან დაკავშირებული პრობლემების საერთაშორისო კლასიფიკატორის მეათე ვერსიას (ICD-10) დაემატა გარდაცვალების ახალი მიზეზი, „U07.1 – ახალი კორონავირუსით გამოწვეული დაავადება (COVID-19), რომელიც ლაბორატორიულად იდენტიფიცირებულია“.
ასევე ნახეთ: „ჩემი ყველაზე საყვარელი გოგო და ყველაზე უმცროსი შვილი“ – მიხეილ სააკაშვილმა ელის მარიას ფოტო გამოაჩინა
ჯანდაცვის მუშაკებს ვირუსის შესახებ დღეს უფრო მეტი ინფორმაცია აქვთ, ვიდრე ვირუსის გავრცელების დასაწყისში, თუმცა კორონავირუსით მაინც ბევრი ადამიანი იღუპება.
ამ მხრივ 2021 წელი საქართველოსთვისაც მძიმე იყო. კორონავირუსით გარდაცვლილთა რიცხვი დღითიდღე იზრდებოდა. პანდემიის დაწყებიდან დღემდე ქვეყენაში 13 800 ადამიანი გარდაიცვალა. აქედან, 2021 წელს ვირუსმა 11 213 ადამიანი იმსხვერპლა.
ბევრად ნაკლები გარდაცვალების შემთხვევა ფიქსირდებოდა 2020 წელს. ამ შემთხვევაში ვირუსით გარდაცვლილთა რაოდენობა 2 587 იყო.























